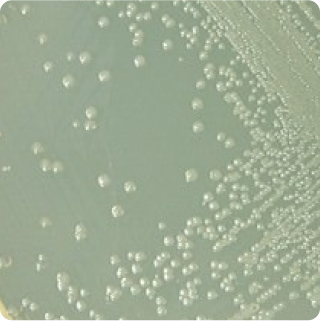

Alicyclobacillus - Quantitative - Plate
ACBQT
|
Turnaround Time:
6 - 8 days

Method Description
Alicyclobacillus spp. are heat-resistant, spore-forming bacteria that survive juice pasteurization temperatures and cause spoilage through production of guaiacol and other off-flavor compounds. The economic impact of contamination incidents can be severe for juice producers, as affected products develop medicinal or antiseptic off-flavors that render entire batches unsaleable. The method uses selective culture media that inhibits competing microorganisms while allowing target bacteria to grow at elevated temperatures.
Analyte List
Technical Data Sheet
Method Name
Enumeration of Alicyclobacillus on BAT Agar Plates
Method Code
LAB-TM-100
Equipment Type
Culture Media - Plate
Equipment Details
Bacillus acidoterrestris Agar
Method Reference
Reportable Unit
CFU/g
Sample Size Requirements
20 grams or 20 milliliters
Available for
Beverages, beverage enhancers, drink powders
Additional Information
Unavailable for
*Prices and offerings are subject to change without notice.